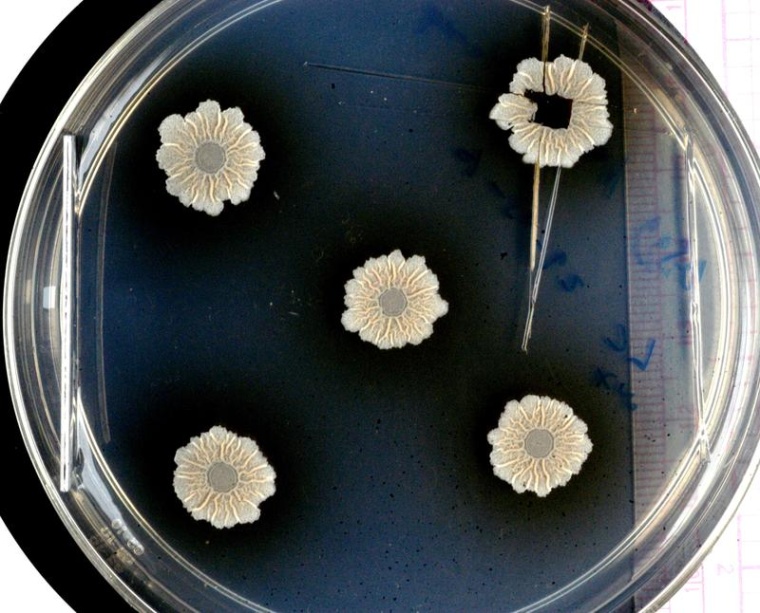
Wenn sich Bakterien zu Gemeinschaften zusammenschließen, können sie komplexe...

Was passiert in Biofilmen?
Ein internationales Team hat ein Modellsystem für Biofilme an der Synchrotronstrahlungsquelle BESSY II am HZB und der ESRF in Grenoble untersucht.
Die meisten Bakterien haben die Fähigkeit, sich zu Gemeinschaften zusammenzuschließen. Sie bilden Biofilme, die auf den unterschiedlichsten Oberflächen haften und schwer zu entfernen sind. Dies kann zu großen Problemen führen, zum Beispiel in Krankenhäusern oder in der Lebensmittelindustrie. Nun hat ein internationales Team unter Leitung der Hebrew University, Jerusalem, und der Technischen Universität Dresden ein Modellsystem für Biofilme an der Synchrotronstrahlungsquelle BESSY II am HZB und der ESRF in Grenoble untersucht und dabei herausgefunden, welche Rolle die Strukturen im Inneren des Biofilms bei der Verteilung von Nährstoffen und Wasser spielen.
Bakterielle Biofilme können auf fast allen Arten von Oberflächen gedeihen: Wir finden sie auf Steinen und Pflanzen, auf Zähnen und Schleimhäuten, aber auch auf Kontaktlinsen, medizinischen Implantaten oder Kathetern, in den Schläuchen der Milchindustrie oder Trinkwasserleitungen, wo sie eine ernsthafte Gefahr für die menschliche Gesundheit darstellen können. Manche Biofilme sind auch nützlich, so sorgen bestimmte Biofilme bei der Herstellung von Käse nicht nur für die vielen winzigen Löcher, sondern auch für den kräftigen Geschmack.
Schutzschicht extrazelluläre Matrix
„Biofilme sind nicht einfach nur eine Ansammlung von sehr vielen Bakterien, sondern ein Gewebe mit besonderen Strukturen", erklärt Prof. Liraz Chai von der Hebrew University in Jerusalem. Gemeinsam bilden die Bakterien eine Schutzschicht aus Kohlenhydraten und Proteinen, die extrazelluläre Matrix. Diese Matrix schützt die Bakterien vor Desinfektionsmitteln, UV-Strahlung oder Austrocknung und sorgt dafür, dass sich Biofilme nur schwer mechanisch entfernen oder chemisch abtöten lassen. Die Matrix ist jedoch kein homogener Schlamm: „Das ist ein bisschen wie in einem Pflanzenblatt, es gibt spezialisierte Strukturen, zum Beispiel Wasserkanäle und winzige Fältchen", sagt Chai.
Doch welche Rolle diese Strukturen spielen und was auf molekularer Ebene in einem Biofilm passiert, war bislang nicht bekannt. Zusammen mit Prof. Yael Politi, TU Dresden, einer Expertin für die Charakterisierung von biologischen Materialien, beantragte Chai daher Messzeit an der Synchrotronstrahlungsquelle BESSY II am HZB. "Das Gute an BESSY II ist, dass wir recht große Flächen abbilden können. Durch die Kombination von Röntgenbeugung und Fluoreszenz können wir nicht nur die molekularen Strukturen im Biofilm sehr genau analysieren, sondern gleichzeitig auch die Anreicherung bestimmter Metallionen, die im Biofilm transportiert werden, verfolgen und etwas über ihre biologische Rolle erfahren", erklärt Yael Politi.
Als Proben verwendeten sie Biofilme aus Bacillus subtilis, einem harmlosen Bakterium, das auf Pflanzenwurzeln gedeiht und mit ihnen eine nützliche Symbiose eingeht: Der Biofilm speichert Wasser, so dass die Pflanze bei Trockenheit vermutlich aus dem Biofilm Feuchtigkeit entnehmen kann, außerdem schützt er die Wurzeln vor Krankheitserregern. Im Gegenzug ernähren sich die Zellen im Biofilm von Wurzelexsudaten. Gleichzeitig sind die Biofilme aus diesem Bakterientyp ein Modellsystem, das für viele Biofilme stehen kann.
Strukturen innerhalb des Biofilms räumlich aufgelöst
An der MySpot-Beamline von BESSY II untersuchten die beiden Expertinnen mit ihren Teams nun eine große Fläche (mm2) aus diesen Biofilmproben. Sie konnten die Strukturen innerhalb des Biofilms räumlich auflösen und gut zwischen Matrixkomponenten, Bakterienzellen, Sporen und Wasser unterscheiden. „Die Röntgenfluoreszenzspektroskopie ist eine Methode, mit der wir wichtige Metallionen wie Kalzium, Zink, Mangan und Eisen auch in Spuren nachweisen können", sagt Dr. Ivo Zizak, HZB-Physiker, der die MySpot-Beamline betreut. So konnte ein Zusammenhang zwischen der Morphologie des Biofilms und der Verteilung der Metallionen hergestellt werden.
Die Auswertung zeigt, dass sich Kalzium-Ionen bevorzugt in der Matrix ansammeln, während sich Zink-, Mangan- und Eisen-Ionen entlang der Falten anreichern, wo sie möglicherweise die Bildung von Sporen auslösen, die für die Ausbreitung der Bakterien wichtig sind.
„Wir haben das nicht erwartet, denn normalerweise bilden sich Sporen unter Stress, z.B. bei Austrocknung. Aber hier sind sie mit Wasserkanälen verbunden, wahrscheinlich durch die Anreicherung von Metallionen", sagt Chai.
Die Ergebnisse zeigen, dass die Strukturen in der Matrix nicht nur eine wichtige Rolle bei der Verteilung von Nährstoffen und Wasser spielen, sondern auch aktiv die Fähigkeit des Bakteriums beeinflussen, sich als mehrzelliger Organismus zu verhalten. „Dies könnte uns helfen, insgesamt mit Biofilmen besser zurecht zu kommen, sowohl mit den nützlichen als auch mit den schädlichen", sagt Liraz Chai.













